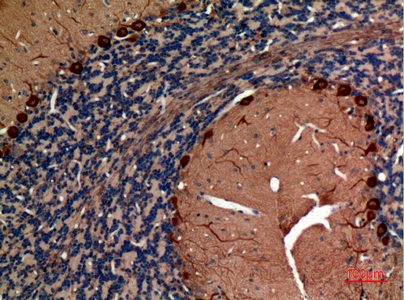
Aldolase C Polyclonal Antibody - Image 3

Aldolase C Polyclonal Antibody
Clonality: Polyclonal
Host: Rabbit
Reactivity: Human, Mouse, Rat
Application: WB, IHC-p, ELISA, TR-FLISA, TR-FRET
Storage: -20°C for 1 year
Conjugation with Bright-Dtech™ on request
![]()
Description
Data sheet Aldolase C Polyclonal Antibody
Background: ALDOC encodes a member of the class I fructose-biphosphate aldolase gene family. Expressed specifically in the hippocampus and Purkinje cells of the brain, the fructose-bisphosphate C is a glycolytic enzyme that catalyzes the reversible aldol cleavage of fructose-1,6-biphosphate and fructose 1-phosphate to dihydroxyacetone phosphate and either glyceraldehyde-3-phosphate or glyceraldehyde, respectively.
Purification: Affinity-purified from rabbit antiserum by affinity-chromatography using epitope-specific immunogen.
Concentration: 1 mg/ml
Formulation: Liquid in PBS containing 50% glycerol, 0.5% BSA and 0.02% sodium azide.
Molecular weight: 39456
Gene ID: Human: 230; Mouse: 11676; Rat: 24191
Synonyms: ALDOC; ALDC; Fructose-bisphosphate aldolase C; Brain-type aldolase
Research area: Neuroscience; Metabolism
Target protein: ALDOC
Additional information
| Weight | 0.7 kg |
|---|---|
| Dimensions | 14 × 15 × 11 cm |
| Size | 20 μL, 50 μL, 100 μL |